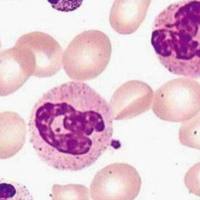
碱性磷酸酶染色(NAP)

万千商家帮你免费找货
0 人在求购买到急需产品
- 详细信息
- 文献和实验
- 技术资料
- 提供商:
上海达为科生物科技有限公司
- 服务名称:
肿瘤组织HE染色服务
| 品牌 | 其他品牌 | 产地类别 | 国产 |
|---|---|---|---|
| 应用领域 | 医疗卫生,生物产业,综合 |
肿瘤组织HE染色服务是达为科生物的基础服务项目之一,由达为科生物经验丰富的实验人员操作完成 。
肿瘤组织HE染色服务
HE染色实验步骤
1.石蜡切片脱蜡至水:依次将切片放入二甲苯I 20min-二甲苯I 20min-无水乙醇I 10min-无水乙醇I 10min-95%酒精5min-90%酒精5min-80%酒精5min-70%酒精5min-蒸馏水洗。2. 苏木素染细胞核:切片入Harris苏木素染3-8min ,自来水洗, 1%的盐酸酒精分化数秒,自来水冲洗, 0.6%氨shui返蓝,流水冲洗。3.伊红染细胞质:切片入伊红染液中染色1-3min。4. 脱水封片:将切片依次放入95%酒精| 5min -95%酒精11 5min-无水乙醇I 5min无水乙醇I 5min -二甲苯I 5min -二甲苯5min中脱水透明,将切片从二甲苯拿出来稍晾干,中性树胶封片。5、显微镜镜检,图像采集分析。
染色结果:细胞核蓝色。细胞质红色。

风险提示:丁香通仅作为第三方平台,为商家信息发布提供平台空间。用户咨询产品时请注意保护个人信息及财产安全,合理判断,谨慎选购商品,商家和用户对交易行为负责。对于医疗器械类产品,请先查证核实企业经营资质和医疗器械产品注册证情况。
文献和实验切片3张以上免制备费 染色服务 类别 服务项目 备注 说明 染色 HE染色 染色 苏木精-伊红染色法,观察组织形态 冰冻HE染色 染色 苏木精-伊红染色法,观察组织形态 油红O染色 染色 4%多聚甲醛固定,冰冻切片。对组织内脂质(如脂滴)染色 番红固绿染色 染色 常用于植物、软骨
外泌体(Exosomes)是细胞分泌到胞外的一种囊泡,大小为 30-150 nm,携带了各种核酸、蛋白质和脂类等物质,可以在不同细胞间进行传递和交流,从而影响受体细胞的生物学功能。 肿瘤细胞来源的外泌体不仅能帮助肿瘤细胞自身发生侵袭和转移,也能促进肿瘤微环境其他细胞的状态发生改变。外泌体在肿瘤中起的作用若要深入研究,这就需要我们拿到更多的肿瘤来源的外泌体。 目前肿瘤方向的研究多使用肿瘤细胞的培养上清来提取外泌体,但是现在我们可以直接利用肿瘤组织来提取外泌体,一方面减少了大量体外
三句话读懂一篇 CNS,胎盘其实更像肿瘤组织,可能是遗传缺陷和不良妊娠之源...
春暖花开好时节,周末阳光明媚,坐在樱花树下了解最新学术进展,不失为一种粉色的浪漫! 本周学术君继续为大家带来 CNS 文章,助力科研顺利! 1. Science Translational Medicine:小细胞外囊泡促进血管生成 血管生成在胚胎发育和体内平衡中起着至关重要的作用,干细胞衍生的小细胞外囊泡(sEVs)被证明能促进心肌梗死(MI)后的血管生成。 2021 年 3 月 10 日,浙江大学医学院附属第二医院胡新央、王建安团队与阿拉巴马大学伯明翰分校张建一团队合作在 Science